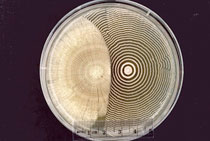
Todar Kenneth Microbiology

Links zu Mikrobiologie Büchern
Auf dieser Seite finden Sie Links zu Büchern aus dem Bereich Mikrobiologie, die wir empfehlenswert finden.
InCelligence* Favorit
|
What's so funny about Microbiology (Deutsch) J. Czichos, Eigenverlag (Deutsch) Jeder, der mit Zellkulturen arbeitet, hat schon mal eine Kontamination gehabt. Für uns sind diese "Störfälle" ärgerlich und nur selten nehmen wir Kontaminationen mit Humor hin. Dieses Comicbuch ist witzig und lehrreich zugleich. Aus der Sicht eines Mikrobiologen werden aus Mikroben und Kontaminanten Lebewesen mit eigener Persönlichkeit und vor allem in dieser Form, mit nicht zu ignorierendem Charme. Vielleicht die Basis für ein wenig Trost beim nächsten "Störfall" ? Preis: ca. 8 Euro bei Amazon oder on-line Reihe bei Wissenschaft Aktuell |
 |
Online Textbook on BacteriologyTodar's Online Textbook on Bacteriology Kenneth Todar, PhD This is a free online textbook put together by Todar Kenneth. It contains all kinds of basic information about bacteriology in general and specific bacterial species, especially pathogenic bacteria. The online book has 5 chapters: Link to Textbook on Bacteriolgy. |
|



